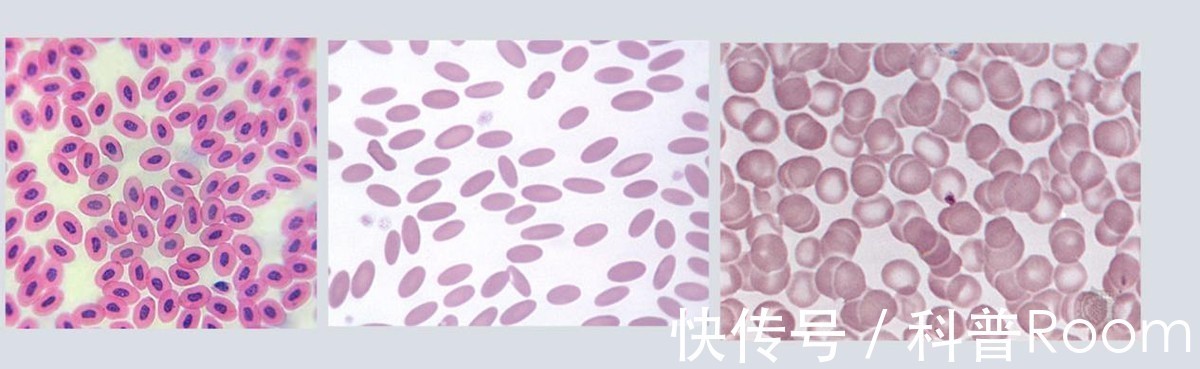

贝尔·格里尔斯在一期《荒野求生》中来到撒哈拉沙漠,他直接划开一头已经发胀的骆驼尸体开始补充能量。但大家有没有听过这样一句话,死去的骆驼碰不到,因为骆驼尸体会发生爆炸,可贝爷却一点事也没有,这是为何?骆驼的嘴巴里会吐出一个粉色的肉球,可为什么吃仙人掌却不会被扎到?接下来就让我带你们一一解答。

骆驼能在沙漠存活原因
想要了解骆驼尸体为何会爆炸,先要了解骆驼为了适应沙漠生活都作出了哪些努力。
骆驼拥有三个胃,其中一个胃有20至30个水脬,可以储存水,并且普通的动物血红细胞是圆形,但骆驼是凹槽椭圆形,这就保证了骆驼在脱水情况下依旧可以流动,也保证了骆驼一次性饮下100升的水而不会因细胞渗透压破裂死亡。并且骆驼的体温从晚上到白天一直在34℃到41℃之间变化,只有高于41℃骆驼才会出汗,这样也会为它们每天节约约5升的水。
最令人感到惊叹的是骆驼鼻内细而弯曲的气道。白天骆驼开始消耗水分时,气道就会分泌出一些黏性物质,这些黏性物质干燥后就会变成硬膜,这时骆驼在呼吸时,就能够将肺内排出的水汽留住,再次吸气时就还能将水送回肺部,阻止水分流失。晚上空气中的水分增加时,气道又能将空气中的水分送到肺部。
鸡 骆驼 人
它们高耸的驼峰是为了储存脂肪,这也保证了骆驼即使一个月不吃不喝,也可以将驼峰内的脂肪进行分解,转化为水和能量。
骆驼尸体爆炸原因
骆驼死掉后,驼峰内还存在未被利用的脂肪,但这时已经没有氧气参与作用,于是在无氧的环境下,脂肪会被大量微生物分解,转化成甲烷、二氧化碳、硫化氢等极具杀伤力的气体。所以即便你发现了骆驼尸体内有水,也不能喝,因为这会导致你的身体产生脱水反应,更严重的还会危及到生命。
加上沙漠的干燥环境,更有利于细菌繁殖,骆驼尸体腐化的速度会非常快,这时厚厚的骆驼皮会包裹住里面的气体,随着时间的推移,尸体内的压强会越来越高,这时的骆驼尸体就会继续膨胀,形成一个圆鼓鼓的球。

此时的尸体更像是一个生化武器,如果你不知危险的上前将刀刺穿骆驼皮肤,就会引发一场“血雨腥风”。
更可怕的是,大量细菌和病毒会跟着毒气和血液喷射而出,如果不幸通过人体黏膜或伤口处进入人体,我们的健康就会受到威胁。
骆驼的粉色“肉球”
大家对骆驼的粉色肉球普遍有两个误解,第一是以为骆驼在吃肉,第二是认为这个骆驼生病了,嘴巴里长出了一个肿瘤。但其实两者都不是,首先,骆驼是纯食草动物,不可能吃任何肉类,其次,这个骆驼也没有生病,这个粉色肉球其实是从骆驼舌根长出来的,也就是它的舌头,而且这也不是一个肉球,因为骆驼的舌头又厚又大,还可以自主伸缩,所以当它将舌头蜷缩起来时,就被我们看成了肉球。但同为纯食草动物,为什么牛、马、羊等生物没有这样的舌头?

这就跟骆驼的生活环境和食物有关了。 由于沙漠恶劣的环境,仙人掌是为数不多能在沙漠存活的植物,于是仙人掌也就成为了骆驼的主要食物。但大家都知道,尽管仙人掌可以补充水分并充当食物,但它浑身长满了尖刺,让人无从下口。
这时就体现出骆驼的优势了,骆驼嘴巴里的皮肤很厚,并且口腔结构比人类两侧多出了密密麻麻非常坚硬的肉刺,这也被称为“乳突”,而且它在咀嚼食物时口腔内还会分泌出一种帮助软化的口水。当骆驼吃仙人掌时,乳突会把仙人掌的刺捋顺到一个方向,然后嚼碎吞到胃里消化,这样不仅能减少疼痛感,还可以保护嘴巴和舌头。

骆驼的大舌头还是雄性骆驼的专属,当秋天求偶期到来时,雄性骆驼会发出“咯咯”的声音,并将粉色的大舌头吐出来吸引雌性骆驼,这时雌性骆驼会通过观察雄性骆驼的大舌头判断它是否值得交配,一旦雌性骆驼接受就会放下身段等待雄性骆驼前来交配。大自然中雄性通过这种方式吸引雌性的还有很多,比如雄性孔雀会通过展示自己美丽的羽毛来吸引雌性的关注。

大自然界中其他动物尸体爆炸
大自然中不能碰的动物尸体可不止骆驼一个。
2004年在台南的一个街道上,一头50吨重的抹香鲸尸体突然爆炸,现场犹如恐怖电影,惨不忍睹。后来经过调查,是因为鲸鱼爆炸的部位曾遭到船只碰撞,这也直接导致鲸鱼在海滩上搁浅死亡并在运输路上因受不了体内腐败所产生的的气体,最终导致爆炸。

大象死后尸体也会因为因大量细菌在内部繁殖而膨胀,这时如果不小心把大象尸体刺破,现场将会惨不忍睹。
结语
至于贝爷为什么没有遭遇爆炸,很有可能是这头骆驼刚死没多久,所以他取出体内的水喝下去也没事,但毕竟贝爷具备足够的知识储备,也拥有大量的实操经验,但大家可没不是贝爷,在野外遇到动物尸体切记要远离哦。

